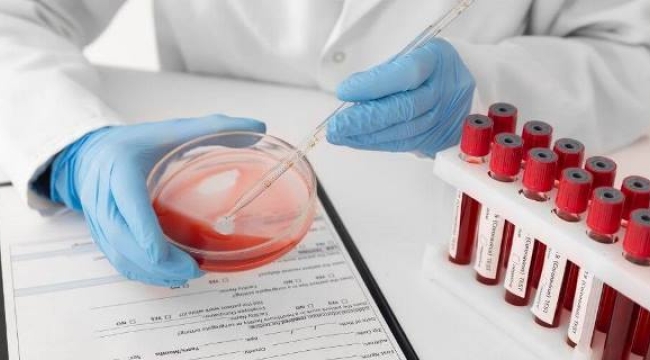

Okullarda bağımlılık taraması başlıyor: Hedef 12-18 yaş
Sağlık Bakanlığı, 12-18 yaş grubuna yönelik bağımlılık taraması ve danışmanlık hizmetini okullarda başlatmak için Millî Eğitim Bakanlığı ile ortak çalışma yürütüyor. Cezaevlerinde ise bağımlı hükümlülere tahliyeden önce tedavi uygulanmasına yönelik pilot programın Bakırköy ve Elâzığ cezaevlerinde başladığı açıklandı.
Editör: Alanya Time - 1
27 Şubat 2026 - 14:47
Sağlık Bakanlığı, çocuk ve gençlerde bağımlılıkla mücadele kapsamında okullarda yeni bir tarama ve danışmanlık modelini devreye almak için hazırlıklarını sürdürüyor. Türkiye Gazetesi'nin haberine göre, Sağlık Bakanı Kemal Memişoğlu, modelin hayata geçirilmesi için Millî Eğitim Bakanlığı ile ortak çalışma yürütüldüğünü bildirdi.
Hedef grup: 12-18 yaş
Meclis Suça Sürüklenen Çocukları Araştırma Komisyonu’nda soruları yanıtlayan Bakan Memişoğlu, özellikle ergenlik dönemi olarak tanımlanan 12-18 yaş grubunun hedef alındığını belirtti. Memişoğlu, tütün, madde ve davranışsal bağımlılıkların erken dönemde tespit edilmesinin amaçlandığını ifade etti.
Bakan Memişoğlu, Kovid-19 salgını sonrasında gençler arasında davranışsal sıkıntıların arttığına dikkat çekerek şunları söyledi:
“Sorun özellikle 12-18 yaş grubunda daha büyük risk oluşturmaya başladı. Okullarda ve liselerde uygulanacak tarama programlarıyla gençlerimize zamanında ulaşmayı hedefliyoruz”
Cezaevlerinde tahliye öncesi tedavi: Pilot program başladı
Bağımlılıkla mücadele kapsamında cezaevlerine yönelik yeni bir uygulamanın da devreye alındığını belirten Bakan Memişoğlu, Sağlık ve Adalet bakanlıkları iş birliğiyle yürütülen pilot program kapsamında, bağımlılık nedeniyle hüküm giymiş kişilere ceza sürelerinin son bir yılına yaklaşırken tedavi verilmeye başlandığını açıkladı.
Memişoğlu, pilot uygulamanın Bakırköy Cezaevi ve Elâzığ Cezaevi’nde sürdürüldüğünü; cezaevlerinde oluşturulan bağımlılık merkezleri aracılığıyla hükümlülerin tedavi sürecine alındığını kaydetti.
Yetkililer, hem okullarda planlanan tarama programlarının hem de cezaevlerinde başlatılan tedavi uygulamasının temel amacının bağımlılığın erken tespiti, tedavisi ve bireylerin topluma sağlıklı şekilde kazandırılması olduğunu belirtti.
Hedef grup: 12-18 yaş
Meclis Suça Sürüklenen Çocukları Araştırma Komisyonu’nda soruları yanıtlayan Bakan Memişoğlu, özellikle ergenlik dönemi olarak tanımlanan 12-18 yaş grubunun hedef alındığını belirtti. Memişoğlu, tütün, madde ve davranışsal bağımlılıkların erken dönemde tespit edilmesinin amaçlandığını ifade etti.
Bakan Memişoğlu, Kovid-19 salgını sonrasında gençler arasında davranışsal sıkıntıların arttığına dikkat çekerek şunları söyledi:
“Sorun özellikle 12-18 yaş grubunda daha büyük risk oluşturmaya başladı. Okullarda ve liselerde uygulanacak tarama programlarıyla gençlerimize zamanında ulaşmayı hedefliyoruz”
Cezaevlerinde tahliye öncesi tedavi: Pilot program başladı
Bağımlılıkla mücadele kapsamında cezaevlerine yönelik yeni bir uygulamanın da devreye alındığını belirten Bakan Memişoğlu, Sağlık ve Adalet bakanlıkları iş birliğiyle yürütülen pilot program kapsamında, bağımlılık nedeniyle hüküm giymiş kişilere ceza sürelerinin son bir yılına yaklaşırken tedavi verilmeye başlandığını açıkladı.
Memişoğlu, pilot uygulamanın Bakırköy Cezaevi ve Elâzığ Cezaevi’nde sürdürüldüğünü; cezaevlerinde oluşturulan bağımlılık merkezleri aracılığıyla hükümlülerin tedavi sürecine alındığını kaydetti.
Yetkililer, hem okullarda planlanan tarama programlarının hem de cezaevlerinde başlatılan tedavi uygulamasının temel amacının bağımlılığın erken tespiti, tedavisi ve bireylerin topluma sağlıklı şekilde kazandırılması olduğunu belirtti.












YORUMLAR